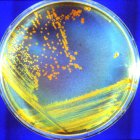
El Deinococcus radiodurans (bautizado como "Conan la Bacteria") está especialmente indicada para sobrevivir al duro entorno de Marte.

Marte es un planeta geológicamente activo
Nuevo estudio ha identificado lo que se considera una pluma de manto activa

Impresión artística de una pluma activa del manto -una gran masa de roca caliente y flotante- que surge de las profundidades de Marte y empuja hacia Elysium Planitia.
La mayor parte de la actividad volcánica y tectónica de Marte se produjo durante sus primeros 1.500 millones de años, pero ahora se le valora como geodinámicamente inerte. Sin embargo, un nuevo estudio ha identificado lo que se considera una pluma de manto activa.
El estudio que publica Nature y encabeza la Universidad de Arizona (Estados Unidos) apunta a que dicha pluma de manto, de unos 4.000 kilómetros de diámetro estaría bajo la Elysium Planitia, en el norte del planeta, la cual empuja la corteza hacia arriba y lleva magma caliente a la superficie.
Esa pluma podría explicar la baja pero constante actividad sísmica, recientemente detectada por el módulo de aterrizaje InSight de la NASA que lleva en Marte desde 2018 y explora una zona denominada Cerberus Fossae.
Es precisamente en esa región donde estaba el volcán más reciente del planeta hace 53.000 años y los autores estiman que allí está también el centro de la pluma.
El equipo encabezado por Adrien Broquet y Jeffrey Andrews-Hanna analizó la topografía, la gravedad y la geología de la región de Elysium Planitia.
A través del uso de modelos geofísicos, encontraron pruebas de que toda la zona se asienta sobre una pluma del manto de material caliente de entre 95 y 285 grados kelvin, más caliente que sus alrededores.
Al igual que en la Tierra, la presencia de una pluma activa impulsa la actividad geológica local sostenida, incluidos los martemotos detectados por InSight, y es la causa de la lenta apertura de la corteza bajo las fosas Cerberus.
Estos hallazgos podrían indicar que Marte es el tercer cuerpo del sistema solar interior, después de la Tierra y Venus, con plumas del manto actualmente activas.